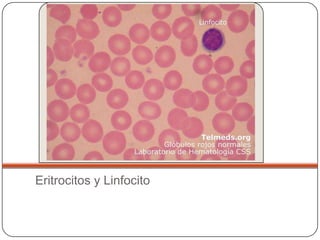
Eritrocitos y Linfocito
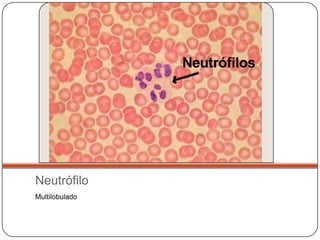
Neutrófilo
Multilobulado
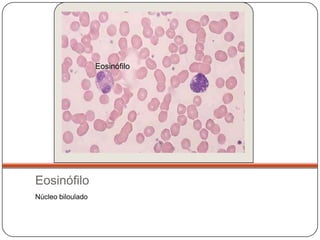
Eosinófilo




Eosinófilo
Núcleo biloulado

Este documento presenta imágenes histológicas de diversos tejidos y órganos del cuerpo humano a diferentes aumentos, incluyendo la tráquea, pulmón, piel, glándula mamaria, glándula tiroides, páncreas, hueso, cordón umbilical, sangre, músculo cardíaco, músculo esquelético, nervio periférico, cerebelo, cerebro, estómago e intestino delgado e intestino grueso.